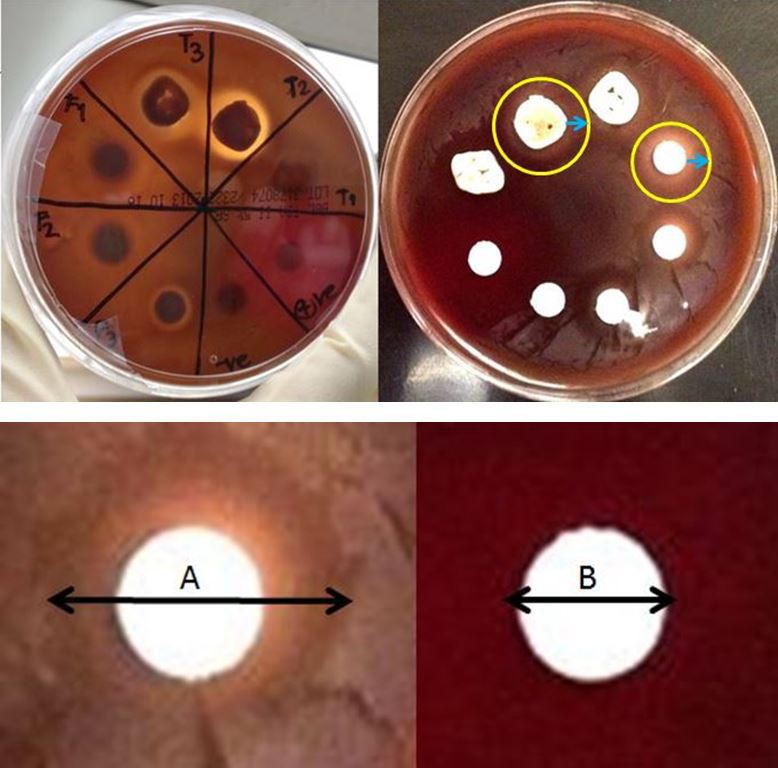
Figure 1 shows a representative plate at one week with very distinct antibacterial properties against streptococcus mutans.  The zone of inhibition is measured as the maximum halo minus the diameter of the tooth section or filter paper disk.

IADR Abstract Archives
Antimicrobial Efficacy of a Novel Anti-Bacterial Bonding Agent
Objectives: The purpose of this study was to investigate the efficacy of a novel anti-bacterial bonding agent on antimicrobial activity against oral pathogens.
Methods: Enamel and dentin disks were cut from freshly extracted human molars perpendicular to the long axis of the teeth with a thin sectioning machine (Isomet). After sectioning, the disks were ethylene oxide sterilized, degassed and stored until use. One surface of the disks were marked and treated with the antibacterial bonding agent containing Bliss Bond-2 (Cao group) and 1,2 or 4% zinc pyrithione.according to the manufacturer’s instruction. Additionally, a filter paper group that was treated similarly were included. Untreated filter paper disks will be used as negative controls. Filter paper disks impregnated with antibiotics were used as positive control.
We used agar-based (zone of inhibition) assays to identify the efficacy (Figure1). We focused on 7 oral species as developed by Guggenheim and is considered by the research community as a “model”. Both the teeth sections and filter paper disks were stored in dd water until the time period for plating. Testing were performed at 1 week, 1 month, 3 month and 6 months. After incubation according to the appropriate periods of time for each microorganism, the inhibition zones were measured. Data were analyzed using two-way ANOVA and Tukey test (α=0.05).
.
Results: One of the bacterial specis, Veilonelle dispa, did not have consistent growth along the time line and was dropped from the stduy. The diameter of the halo diminished along the time line. The zone of inhibition appears to be dose dependent (Figure 2). The agents also showed varying efficacy against different species of bacteria. It was most effective against Streptococcus mutans, Streptococcus gordonii and Actinomyceces viscosus; it was minimally effective against Lactobacillus casei, Porphyromonas gingivalis and Fusobacterium nucleatum. The observed minimal inhibition may be an effect of the slower growth of the strict anaerobic species; the inhibition zones do not always have clear or regular boundaries.
Conclusions: Bliss Bond-2 containing 1, 2 or 4% zinc pyrithione appears to have antibacterial properties agaianst some species of bacteria tested up to 6 months. 4% zinc pyrithione showed the most consistent effect along the time line.
Methods: Enamel and dentin disks were cut from freshly extracted human molars perpendicular to the long axis of the teeth with a thin sectioning machine (Isomet). After sectioning, the disks were ethylene oxide sterilized, degassed and stored until use. One surface of the disks were marked and treated with the antibacterial bonding agent containing Bliss Bond-2 (Cao group) and 1,2 or 4% zinc pyrithione.according to the manufacturer’s instruction. Additionally, a filter paper group that was treated similarly were included. Untreated filter paper disks will be used as negative controls. Filter paper disks impregnated with antibiotics were used as positive control.
We used agar-based (zone of inhibition) assays to identify the efficacy (Figure1). We focused on 7 oral species as developed by Guggenheim and is considered by the research community as a “model”. Both the teeth sections and filter paper disks were stored in dd water until the time period for plating. Testing were performed at 1 week, 1 month, 3 month and 6 months. After incubation according to the appropriate periods of time for each microorganism, the inhibition zones were measured. Data were analyzed using two-way ANOVA and Tukey test (α=0.05).
.
Results: One of the bacterial specis, Veilonelle dispa, did not have consistent growth along the time line and was dropped from the stduy. The diameter of the halo diminished along the time line. The zone of inhibition appears to be dose dependent (Figure 2). The agents also showed varying efficacy against different species of bacteria. It was most effective against Streptococcus mutans, Streptococcus gordonii and Actinomyceces viscosus; it was minimally effective against Lactobacillus casei, Porphyromonas gingivalis and Fusobacterium nucleatum. The observed minimal inhibition may be an effect of the slower growth of the strict anaerobic species; the inhibition zones do not always have clear or regular boundaries.
Conclusions: Bliss Bond-2 containing 1, 2 or 4% zinc pyrithione appears to have antibacterial properties agaianst some species of bacteria tested up to 6 months. 4% zinc pyrithione showed the most consistent effect along the time line.